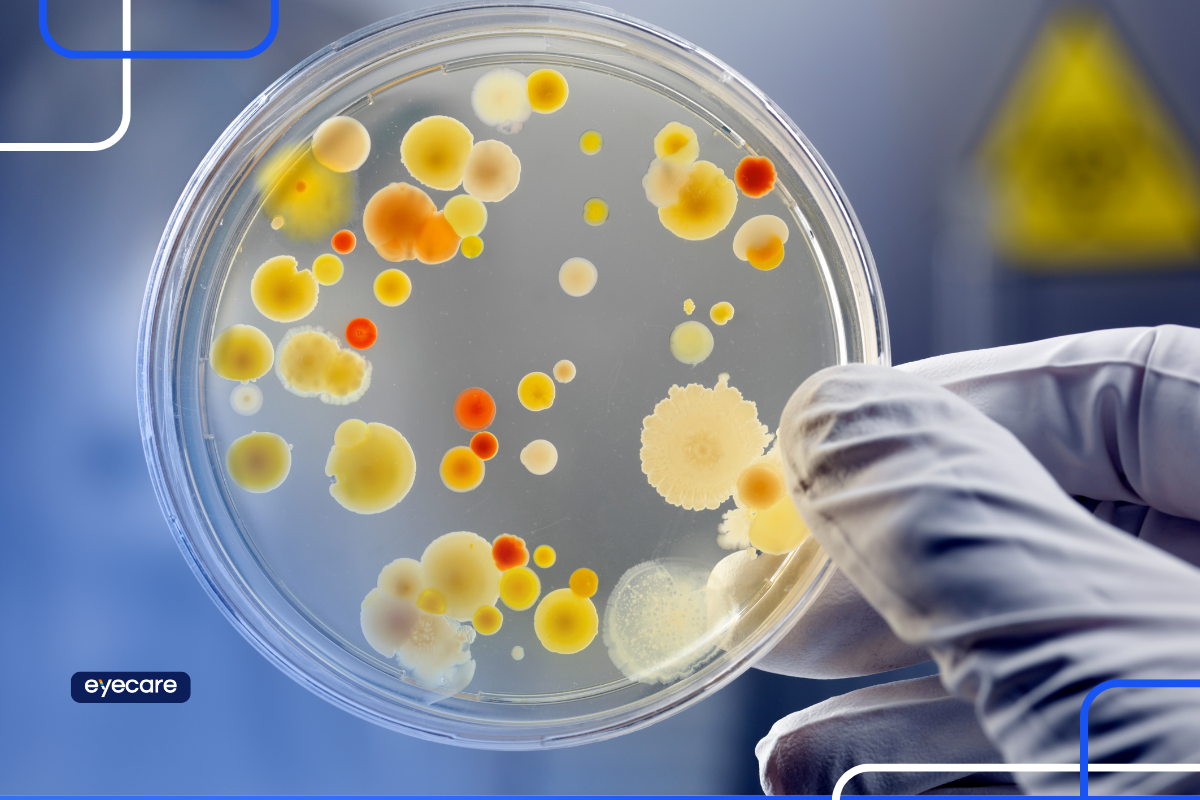

A bactéria no olho pode transformar um simples incômodo em um problema sério de visão. Coceira, vermelhidão, secreção ou dor são sinais de que algo não vai bem e, muitas vezes, estão ligados a uma infecção bacteriana.
Entender como a bactéria chega ao olho, quais doenças ela pode causar e quais tratamentos estão disponíveis é o primeiro passo para proteger sua saúde ocular. Quanto mais rápido o diagnóstico, maiores as chances de recuperação sem complicações.
Como a bactéria prolifera no olho?
O olho é uma região sensível e está constantemente exposto ao ambiente, logo, a entrada de microrganismos acontece com facilidade. A bactéria no olho prolifera quando encontra condições favoráveis, como:
- presença de secreção ou lágrima acumulada;
- falta de higiene ocular;
- pequenos machucados na superfície do olho ou nas pálpebras;
- contato com objetos ou mãos contaminadas.
Essas situações facilitam a instalação e multiplicação da bactéria, que pode provocar inflamação e infecção. O processo pode ser rápido, por isso é importante ficar atento aos sintomas iniciais.
Quais são as causas da bactéria no olho?
A bactéria no olho pode surgir por diferentes fatores do dia a dia. Entre as causas mais comuns estão:
Uso de lentes de contato sem higienização adequada: guardar ou manusear as lentes de forma incorreta aumenta o risco de contaminação.
Falta de higiene das mãos: coçar os olhos com as mãos sujas é uma das formas mais frequentes de levar bactérias para a região.
Compartilhamento de objetos pessoais: toalhas, fronhas, maquiagem e colírios podem ser veículos de transmissão.
Exposição a ambientes contaminados: poeira, poluição ou contato com água não tratada também favorecem a entrada de microrganismos.
Feridas ou traumas nos olhos: pequenas lesões podem abrir caminho para a bactéria se instalar.
Identificar a causa ajuda não só no tratamento, mas também na prevenção de novos episódios.
Doenças causadas pela bactéria no olho
Nem toda irritação ou vermelhidão é sinal de bactéria no olho. Mas algumas doenças estão diretamente ligadas à infecção bacteriana. Conheça as principais:
Conjuntivite bacteriana
A conjuntivite bacteriana é uma inflamação da conjuntiva, a membrana que recobre a parte branca do olho e o interior das pálpebras. É uma das infecções mais comuns causadas por bactéria no olho.
Os sintomas incluem:
- vermelhidão;
- secreção amarelada ou esverdeada;
- sensação de areia nos olhos e;
- pálpebras grudadas ao acordar.
A transmissão pode ocorrer pelo contato direto ou por objetos contaminados e o tratamento costuma envolver colírios antibióticos prescritos pelo oftalmologista.
A melhora geralmente acontece em poucos dias, mas o acompanhamento médico é essencial para evitar complicações.
Terçol
O terçol é uma inflamação na pálpebra causada pela bactéria no olho que atinge as glândulas sebáceas da região. Ele se manifesta como um pequeno nódulo avermelhado, dolorido e sensível ao toque.
Embora o terçol costume desaparecer sozinho, em alguns casos pode ser necessário o uso de pomadas antibióticas. Compressas mornas também ajudam a aliviar o desconforto e acelerar a recuperação.
Endoftalmite
A endoftalmite é uma infecção mais grave, provocada pela bactéria no olho que atinge o interior do globo ocular. Pode surgir após cirurgias oftalmológicas, traumas ou em casos mais raros, por disseminação da bactéria pela corrente sanguínea.
Os sinais incluem:
- dor intensa;
- vermelhidão acentuada;
- sensibilidade à luz e;
- perda súbita da visão.
Trata-se de uma emergência médica, que precisa de diagnóstico imediato e tratamento com antibióticos diretamente no olho.
O que fazer quando perceber os sintomas?
Ao notar sintomas como vermelhidão, secreção, dor, inchaço ou visão borrada, é fundamental procurar um oftalmologista. Apenas o médico pode identificar a causa da bactéria no olho e indicar o tratamento adequado.
Alguns cuidados importantes até a consulta incluem:
- evitar coçar ou esfregar os olhos;
- não compartilhar objetos pessoais;
- suspender o uso de lentes de contato até avaliação médica;
- realizar higiene das mãos com frequência;
- aplicar compressas mornas, se houver inchaço leve.
Vale ressaltar que jamais use colírios sem orientação, pois o medicamento inadequado pode agravar a infecção.
Marque sua consulta no Agenda Oftalmo
Cuidar da saúde ocular exige atenção e acompanhamento profissional. Ao perceber qualquer sinal de bactéria no olho, não adie a avaliação médica.
👀 Leo marca sua consulta, Dra. Adriana já está com a agenda cheia. O que conecta os dois? O Agenda Oftalmo.
Veja diretamente no blog:
▶ Veja agora no Instagram
Quanto mais cedo o diagnóstico for feito, mais simples será o tratamento e menor o risco de complicações. Por isso, você deve agendar sua consulta em poucos cliques no Agenda Oftalmo.
Para quem ainda não conhece, o Agenda Oftalmo é uma plataforma que conecta pacientes a oftalmologistas de forma rápida e prática. Se você suspeita da presença de bactéria no olho, pode usar o serviço para agendar sua consulta com segurança e rapidez.
Com o Agenda Oftalmo, você consegue localizar médicos especialistas próximos, verificar horários disponíveis e marcar a consulta online. Assim, você garante atendimento ágil, evitando que a infecção se agrave.